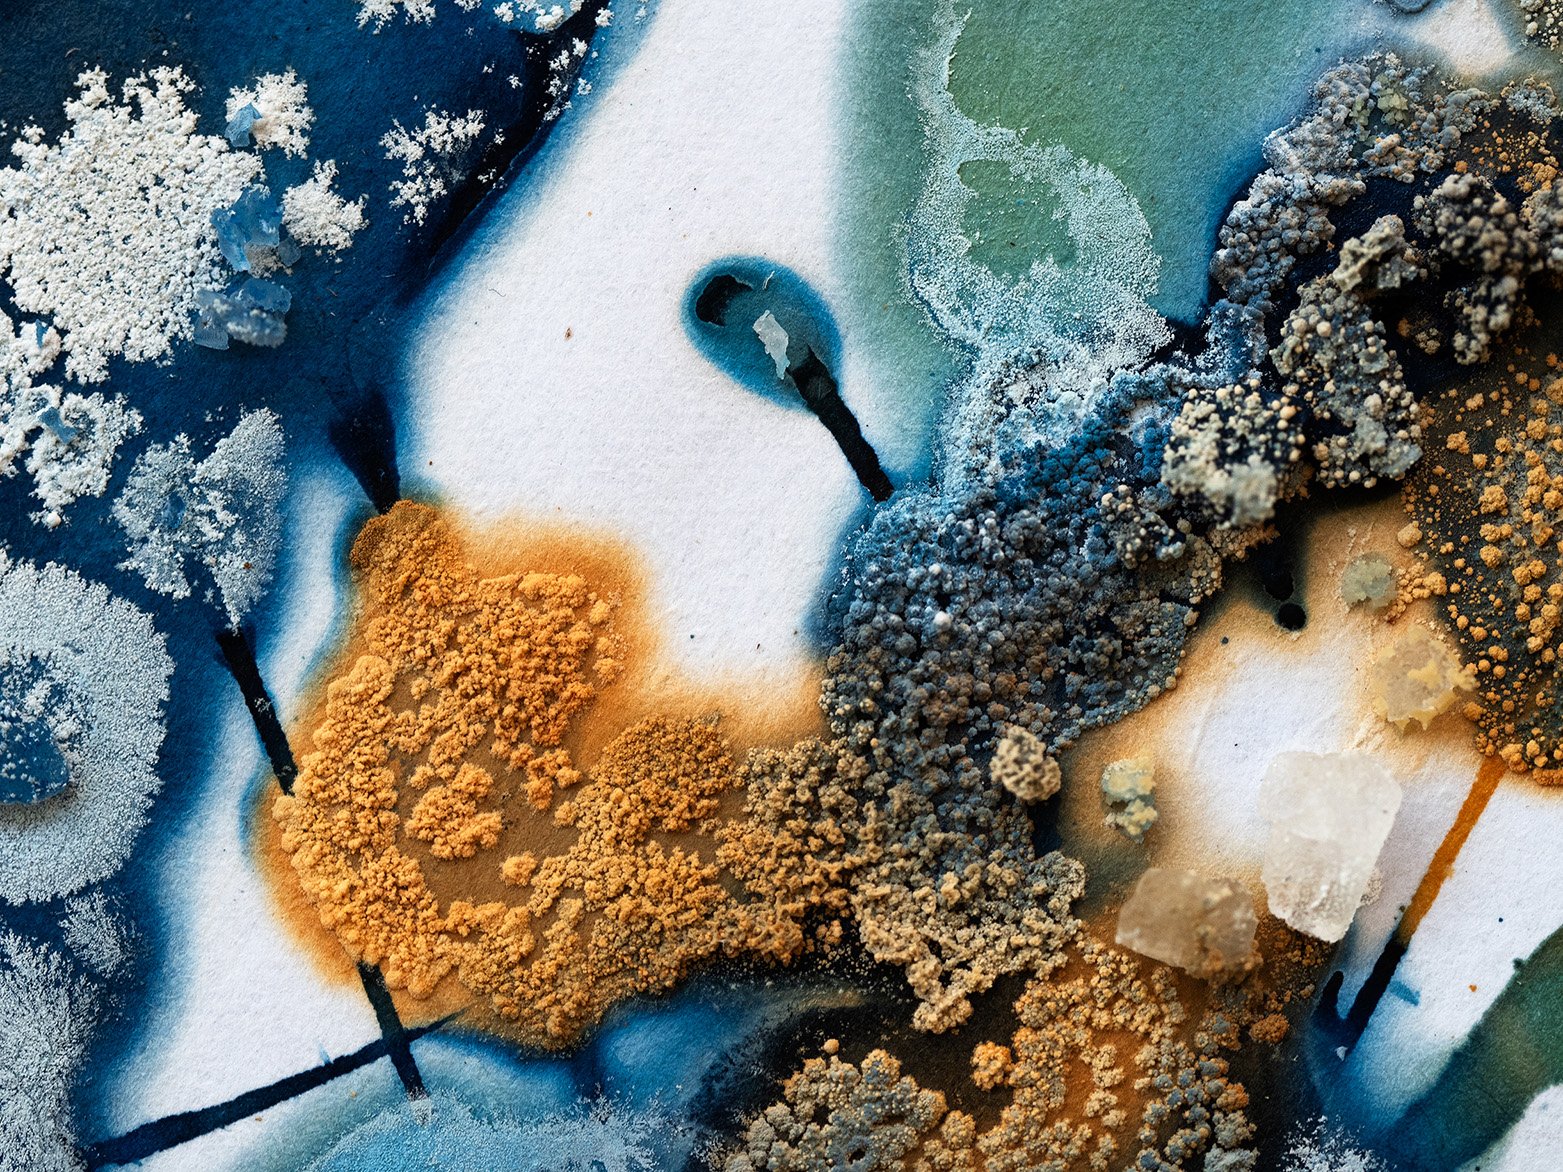

Collaborations
We are a living, breathing archaeological site. Dig deep enough into our genetic make-up and you will find remnants of our ancestors
Archaeology Influencing Music Creation, 2021
Inspired by the links between archaeology, heavy metal and grunge music (especially relating to the artwork on album covers) yet considering the modern industrial landscape as though having time-travelled to the future from the Neolithic and wondering how they would interpret the things that they saw.
I took a series of photographs relating to modern industry and listened to heavy metal music whilst painting the backgrounds for the CD cover. The images were scanned and sent electronically to my collaborator who then used digital brushes to overlay stylised imagery on the background, before adding the band name and song titles that we had invented. I used sections of the painted background to produce a CD label and the inside of the CD sleeve.

Inspiration for the industrial elements for the CD cover

CD sleeve and CD label
Agency of the Elements
This was a collaboration between four artists and archaeologists as part of our MA Contemporary Art and Archaeology course. We each selected one of the elements (Earth, Wind, Fire and Water) and considered how their agency might affect both the landscape and the archaeology. Concentrating on the element of Wind, I created pieces relating to memory, time, place and a sense of belonging.

Commissions
AB-Tree
In October 2018 I was commissioned to paint the Celtic style tree on the canteen wall at the Scottish School of Forestry, Inverness. The ‘tree’ was used by writer Mandy Haggith, and the staff and students as a means of exchanging information concerning the trees and shrubs associated with the Gaelic alphabet.